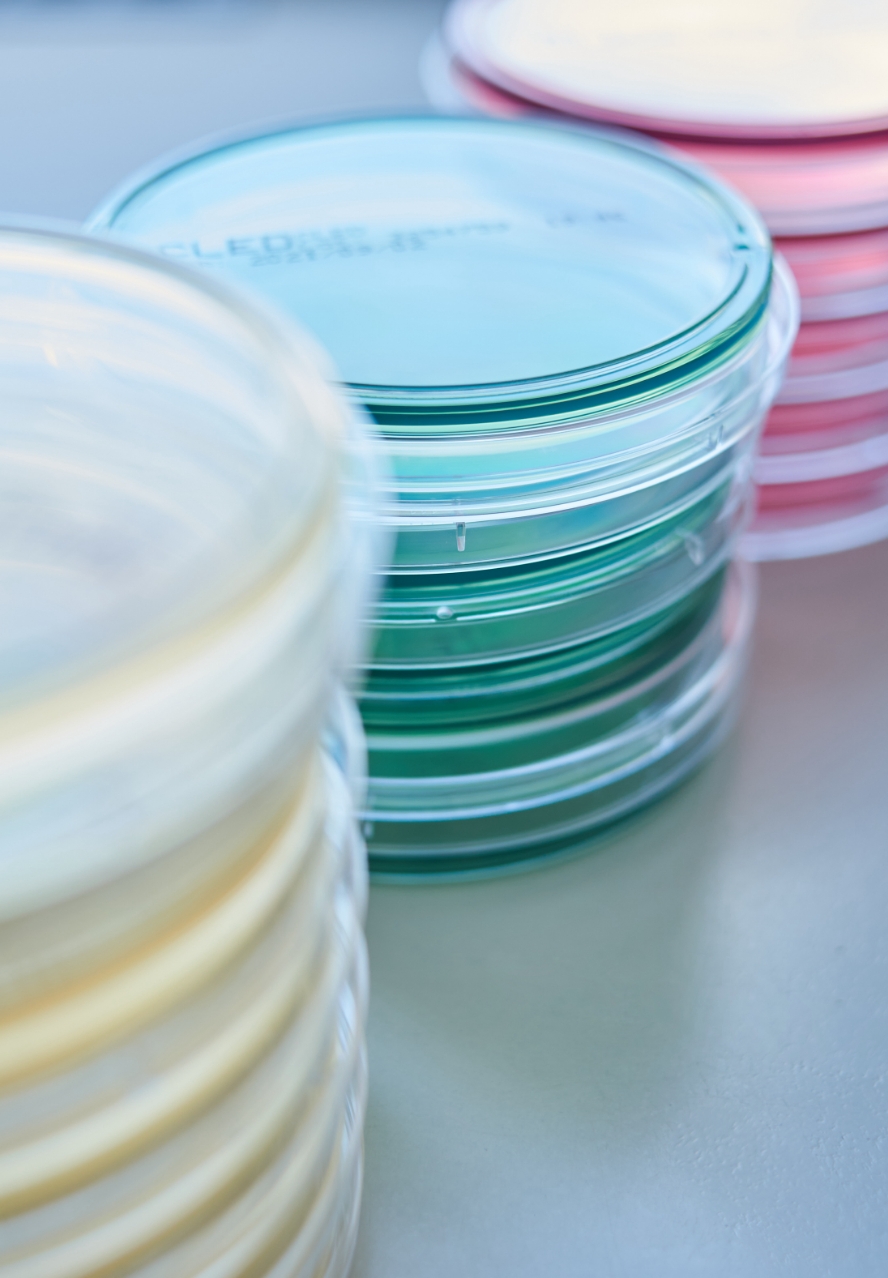

Facharzt für Urologie
Medikamentöse Tumortherapie SPRECHZEITEN
- Mo bis Fr8.30 – 12.30 Uhr
- Mo und Do15.00 – 17.00 Uhr
- Di15.00 – 18.00 Uhr


Herzlich willkommen …
… in unserer Praxis für Urologie in Hattersheim. Wir betreuen Frauen, Männer und Kinder und sind Ihr erster Ansprechpartner bei allen urologischen Anliegen. Dazu gehören sämtliche Untersuchungen und Behandlungen der Niere, Blase und Harnwege. Aber auch bei Beschwerden im Bereich der männlichen Geschlechtsorgane helfen wir ihnen gerne weiter. Wir behandeln Sie in einer ruhigen, freundlichen und diskreten Atmosphäre nach neuestem Stand der Medizin.
Urologisch-fachärztliche Kompetenz, Erfahrung sowie moderne medizinische Diagnostik und Therapie sind das Fundament meiner Praxis. Ein sensibler und verständnisvoller Umgang mit Ihren Beschwerden und Sorgen ist für mein Team und mich selbstverständlich. Wir behandeln Ihre Anliegen mit Diskretion und möchten, dass Sie sich zu jedem Zeitpunkt über Ihre Behandlung gut informiert fühlen. Deshalb stellen wir Ihnen alle Behandlungsmöglichkeiten vor, die in Ihrem individuellen Fall zur Verfügung stehen.
Wir freuen uns, wenn auch Sie uns Ihr Vertrauen schenken und wir in unserer Praxis in Hattersheim persönlich für Sie da sein dürfen.
Ihr Samuel Khalil und Team
Praxis

Die urologische Praxis in Hattersheim wurde 1988 von meinem Vater Dr. med. Mahrous Khalil gegründet und von 2015 bis 2019 fünf Jahre als Gemeinschaftspraxis von uns beiden geführt. Dabei konnte ich immer von der Erfahrung meines Vaters profitieren. Seit April 2022 bereichert meine kompetente Kollegin Frau Dr. med. Mariam Wishahi unser Team.
In einem engen fachlichen Austausch stehe ich mit unserer Partnerpraxis in Hochheim am Main, welche von meinem Bruder Christian Khalil geführt wird.
Meine Praxis in Hattersheim befindet sich im Gebäude der „Krone“, einem der ältesten Gasthäuser der Stadt. Wo heute Patientinnen und Patienten behandelt werden, war früher der große Festsaal.
Unsere Praxis ist modern und mit der neuesten Technik ausgestattet. So können wir Ihnen eine in jeder Hinsicht optimale Behandlung bieten. Medizinisch indizierte fachurologische Laboruntersuchungen führen wir direkt in unserer Praxis durch. Entsprechend schnell und zuverlässig liegen die Ergebnisse vor.
Im Erdgeschoss haben wir für Sie einen barrierefreien Untersuchungsraum. Bitte sprechen Sie uns an, wenn Sie dort behandelt werden möchten. Auch Hausbesuche führen wir durch. Sollten Sie hierzu Fragen haben, kontaktieren Sie uns gerne.
Team
Wir haben einen hohen Anspruch an unsere tägliche Praxisarbeit und wollen, dass Sie sich bei uns gut aufgehoben fühlen.
Unser professionelles Team kümmert sich daher mit viel Freude, Einfühlungsvermögen und nach geltenden Leitlinien zuverlässig um Sie und Ihre Gesundheit. Einige Mitarbeiterinnen sind schon fast 30 Jahre mit an Bord.
Ein empathisches und offenes Gespräch zu Beginn Ihres Besuchs schafft gegenseitiges Vertrauen und ist der Grundstein für alle weiteren diagnostischen und therapeutischen Schritte.
-
SAMUEL KHALIL
2003 bis 2009: Studium der Humanmedizin an der Universität Mainz
2009 bis 2014: Facharztausbildung am Klinikum Bremen-Mitte, Urologische Klinik / Transplantationszentrum, Prostatakrebszentrum
Mai 2014: Fellowship of European Board of Urology
2014 bis 2015: Tätigkeit als Facharzt der Urologie am Klinikum Bremen-Mitte, Urologische Klinik / Transplantationszentrum, Prostatakrebszentrum -
DR. MED. MARIAM RIASOL WISHAHI
seit 2022 Fachärztin in der Urologie Hattersheim am Main
2021 Fellow of the European Board of Urology
2019 bis 2022 Fachärztin für Urologie, Klinik Bad Soden
2014 bis 2019 Urologische Facharztausbildung (Sankt Katharinen Krankenhaus Frankfurt, Klinikum Offenbach, Klinik Bad Soden)
2013 Promotion an der Urologischen Klinik und Poliklinik der Universitätsmedizin Mainz
2006 bis 2013 Medizinstudium in Mainz/Deutschland, Dijon/Frankreich, North Carolina/USA, Kairo/Ägypten -
DR. MED. JANE ALEXANDRA GERDES
-
AZIZE ARTA
in der Praxis tätig seit April 1991Schwerpunkte:
• Onkologie
• Andrologie
• Endoskopie
• Labor
• OP-Assistenz -
ANN-CHRISTIN KRELL
in der Praxis tätig seit August 2010Schwerpunkte:
• Nicht-ärztliche Praxisassistenz
• Labor
• Anmeldung
• Endoskopie
• Hygieneweiterbildung -
RENATE RESCHKEWITZ
in der Praxis tätig seit August 1990Schwerpunkte:
• Anmeldung
• OP-Assistenz
• Endoskopie
• Hygienebeauftragte -
MADELINE KRELL
MFA Ausbildung seit 2024
Leistungs- und
Behandlungs-Spektrum
von A bis Z
Sprechzeiten
Unsere Praxis ist zu folgenden Zeiten für Sie geöffnet:
- Mo bis Fr8.30 – 12.30 Uhr
- Mo und Do15.00 – 17.00 Uhr
- Di15.00 – 18.00 Uhr
Bei Bedarf führen wir Hausbesuche durch. Bitte sprechen Sie uns darauf an.
Anfahrt
mit Bus & Bahn
Nutzen Sie den Service des RMV und planen Sie Ihre Anreise von Ihrm Standpunkt aus.
Anreise planenKontakt
Sie haben einen Rezeptwunsch oder möchten einen Termin vereinbaren? Kontaktieren Sie uns gerne über unser Kontaktformular oder telefonisch.
Urologie HATTERSHEIM AM MAIN
Überörtliche Berufsausübungsgemeinschaft
Dr. med. Uta Scheerbaum – Samuel Khalil
Hauptstraße 16
65795 Hattersheim am Main
T 06190 2602
F 06190 73245
praxis@urologie-hattersheim.de